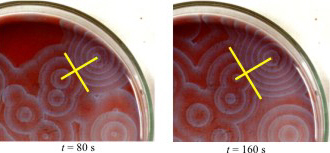

May 9, 2019
Having a staff member sat idle at an empty checkout lane feels wasteful.
So the company policy is to train staff to do everything in the store, so when its quiet, they can be re-stocking, tidying up or whatever else needs to be done. When it gets busy, people jump back onto their checkouts to quickly get the queue down.
Not a bad policy, provided you have enough people.
But having a staff member sat idle at an empty checkout lane, or casting about for something to do still feels wasteful. So its tempting to the store manager to cut the total number of people. “We have a self-checkout people can use, so unless its really busy, we don’t need any other checkout open, and I can handle that – I can make more profit with a smaller team.”
Now you’ve introduced a bottleneck for customers, a bottleneck some of them are going to dislike so much they will stop shopping with you, despite all the changing stock you put in to encourage return visits, browsing and impluse buys.
Your shop gets less busy, so you cut down further on staffing levels. The queues at the self-checkout get longer, the queue at the manned checkout even longer.
Suddenly you’re hardly ever busy, and company management are wondering whether your store is viable.
3 points:
-
Checking out is merely one step in the customers’ cyclical process of shopping. Before optimising any step, consider its impact on the process as a whole.
-
A store is a system designed to enable that process for the people you serve locally. All systems need slack if they are to work efficiently.
-
A store is part of a larger company system designed to make and keep a particular promise to a particular set of people. Before optimising anything, consider whether it will reinforce that promise or undermine it.
It is of course perfectly OK to put some people off shopping with you – so long as you do it on purpose, and only to the right people.